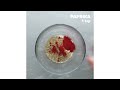

Roasted Garlic Parmesan Potatoes
Servings: 4 - 6
INGREDIENTS
3 russet potatoes, sliced
4 tablespoons olive oil
Salt, to taste
Pepper, to taste
2 teaspoons garlic powder
2 teaspoons Italian seasoning
1 teaspoon paprika
½ cup parmesan cheese, shredded
Parsley, chopped
PREPARATION
1. Preheat the oven to 400˚F / 200˚C.
2. Place the potatoes in a large bowl. Drizzle olive oil and toss to coat.
3. In a small bowl, mix salt, garlic powder, Italian seasoning, and paprika. Sprinkle seasoning on potatoes and toss to coat.
4. Spread the potatoes on a baking sheet. Bake for 30 minutes, remove from the oven, sprinkle with parmesan and pepper, then bake for an additional 20 minutes.
5. Sprinkle potatoes with fresh parsley and serve while hot.
6. Enjoy!
MUSIC
Can’t Stop
Licensed via Audio Network
Made by BFMP www.buzzfeed.com/videoteam
Roasted Garlic Parmesan Potatoes ─ Tasty
<style>.embed-container { position: relative; padding-bottom: 56.25%; height: 0; overflow: hidden; max-width: 100%; } .embed-container iframe, .embed-container object, .embed-container embed { position: absolute; top: 0; left: 0; width: 100%; height: 100%; }</style><div class="embed-container"><iframe src="http://www.youtube.com/embed/9rCVKl87qys" frameborder="0" allowfullscreen></iframe></div>
Posted by
Han Book
at
3:46 AM